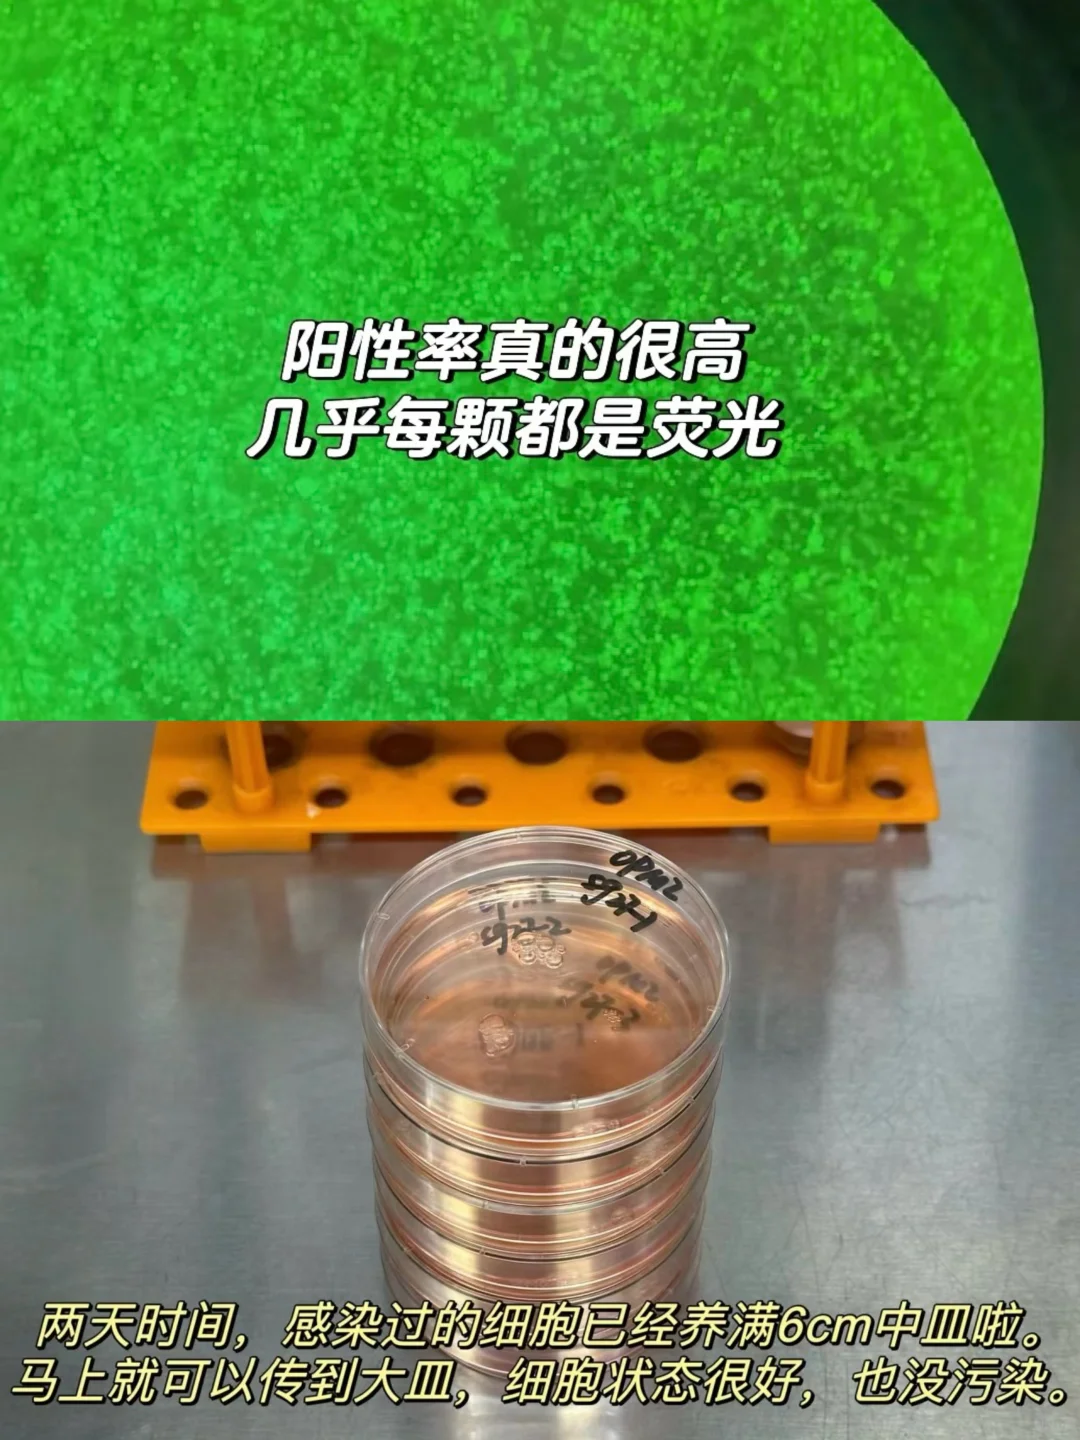

🫡这篇笔记包括慢病毒包装protocol和注意事项,慢病毒感染细胞tips,以及构建稳株和嘌呤霉素筛选要点。(第三四张图)
从包装病毒到收集病毒,筛选稳株整个流程的一套干货都给大家出了,码住‼️
🦠自配慢病毒浓缩液配方:
PEG8000: 44g,定容至100ml
4M NaCl:23.4g,定容至100ml
用自配的浓缩液的话,大家根据我写的protocol和tips,感染效果也不会差。👻
👾滤头的使用:
1、如果包病毒过程出现黑胶虫,用0.22um的,会更干净不易污染,但可能会损失一部分病毒;
2、如果包病毒过程中细胞依旧很干净,用0.45um的即可。
🫙离心管:比克曼的,好用不贵。
👉🏻收集病毒建议采用50ml离心管,别用15ml离心管,好用方便管内空间大,浓缩过程会更好的结合病毒颗粒,提高浓缩率。
👉🏻离心管使用前一定要检查是否破损,盖子旋钮是否密不透风!之前用某品牌摇床摇的时候半夜漏液了,漏了一地,明明拧紧的,原来是底部裂了一条细小的缝没发现,品控太差…
🫡之前撸到的羊毛,比克曼家的50ml离心管就很好用🤗🤗🤗强推!!
原来用的某思,一整包里偶尔会出现几个破的…最离谱的是,离心管装液体后放负20冻几天,盖子就裂了…这款完全不会~而且盖子螺旋处很好扭,也很结实!🤗

退退
计算机专业成长偏方?我包病毒的技能都能拿出来秀了,你们呢?
又幾重
自配慢病毒浓缩液配方?滤头使用注意事项?这篇笔记干货满满,值得收藏学习
Mr . way
原来自己包装慢病毒也能高效率,get到了新技能,不过滤头和离心管的选择好讲究啊